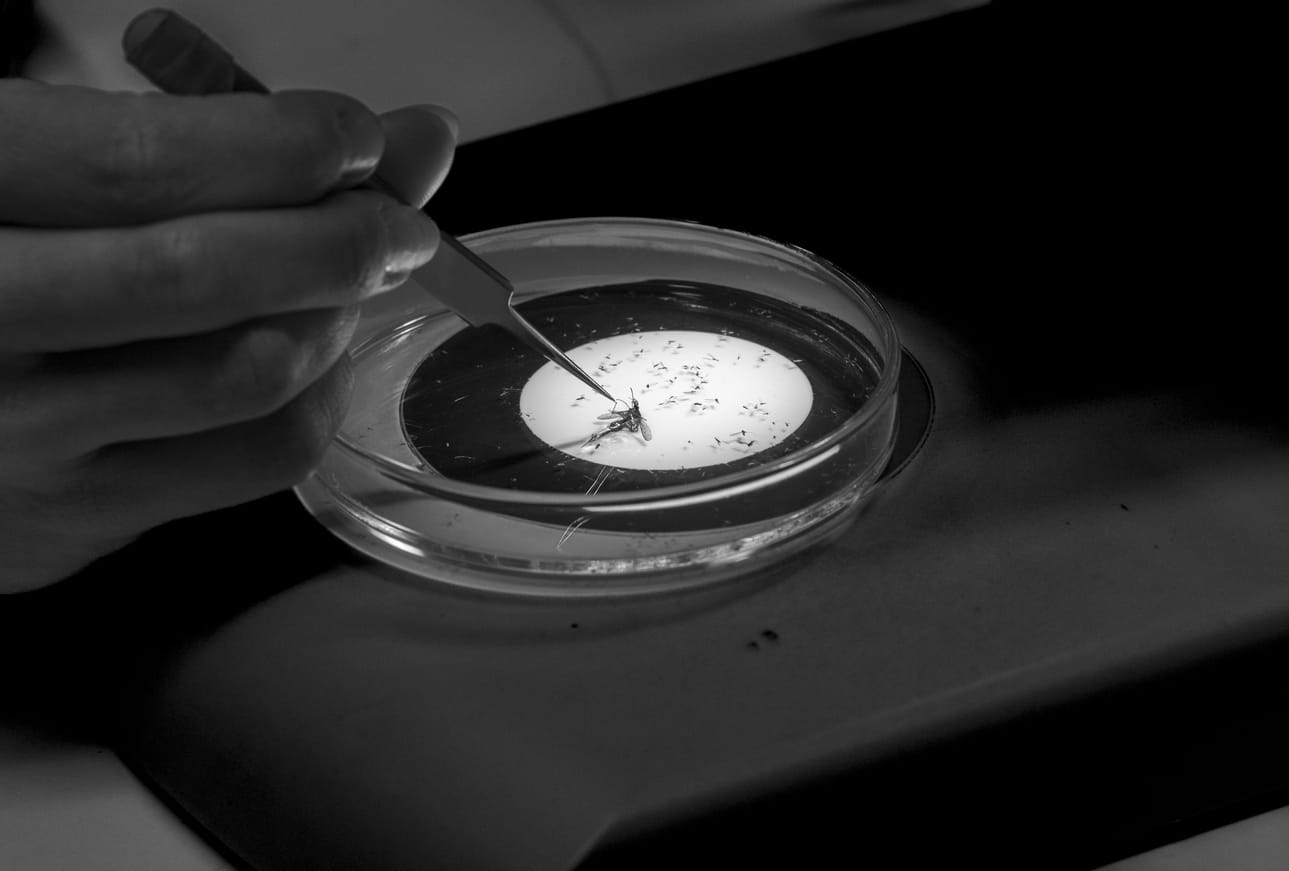
-

Viisitoista vuotta sitten tätä olisi pidetty scifinä, siis tieteisfiktiona.
Apulaisprofessori Stefan Prostin kädessä oleva dna-lukulaite on pienempi kuin television kaukosäädin, mutta se kykenee ihmeellisiin asioihin.
Pieni kokkare liito-oravan jätöstä riittää tunnistamaan yksilön, mitä se on syönyt, mitkä ovat sukulaisuussuhteet, suurin piirtein myös iän.
– Pienestä kakasta voi selvitä todella paljon.